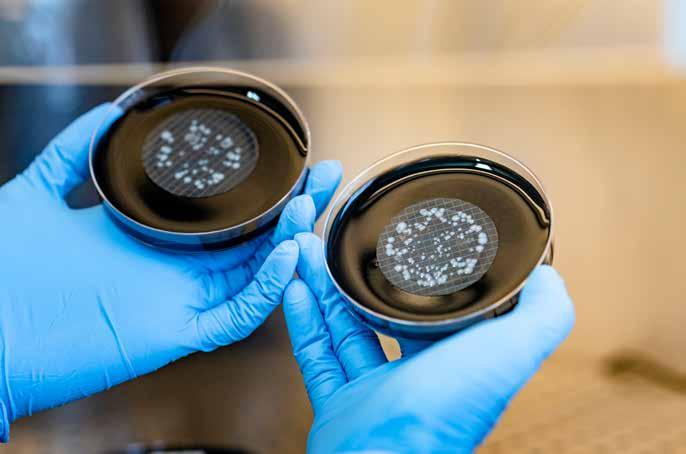

Alutech Dach ultra è il pannello Alubel capace di raggiunge un nuovo traguardo nella reazione al fuoco con REI FINO A 60 MINUTI senza alcun fissaggio inferiore di cucitura.
Rispetto al pannello coibentato Alutech Dach standard, Alutech Dach ultra incrementa il potere TERMOISOLANTE FINO AD UN + 20%.


L’innovativo giunto laterale permette un perfetto accoppiamento tra i pannelli e RIDUCE LE PROBLEMATICHE relative alla CONDENSA.

Editoriale
Le cosiddette Life Skills sono una gamma di abilità cognitive, emotive e relazionali che consentono alle persone di operare con competenza sia sul piano individuale sia su quello sociale. Sono abilità e capacità che permettono di acquisire un comportamento versatile e positivo, grazie al quale si possono affrontare efficacemente le richieste e le sfide della vita quotidiana.
Le 10 Life Skills identificate dall’Oms sono: consapevolezza di sé, gestione delle emozioni, gestione dello stress, comunicazione efficace, relazioni efficaci, empatia, pensiero creativo, pensiero critico, prendere decisioni, risolvere problemi. Per gestire efficacemente il Condominio occorrono molte di queste Life Skills e per avere una comunità condominiale che si senta al sicuro è bene averle tutte. In questo numero alcune delle situazioni ricorrenti che vanno gestite con competenza e programmazione.
Allarme legionella
Per esempio, la cronaca milanese negli ultimi mesi ha registrato molti casi di legionella che hanno messo a dura prova la capacità degli amministratori di Condominio di comunicare con tempestività e positività la gestione dell’allarme contaminazione e i relativi comportamenti da far tenere ai condòmini.
La nostra storia di copertina rassicura su questo fronte. Esistono, infatti, aziende come Csdm che fondano la propria attività sulla prevenzione, con il duplice obiettivo di tutelare e assistere nelle sue funzioni l’amministratore e mettere in sicurezza il condominio, tutelando la salute dei condòmini.
Sorveglianza e videorveglianza
In Condominio Sicurezza è anche Sorveglianza e Videorveglianza. E quest’ultima pone non pochi problemi legati alla privacy. In un articolo dell’avv. Carlo Pikler si fa il punto sulla normativa e sulla giurisprudenza.
Impianti elevatori
Sicurezza in Condominio è anche salire e scendere senza correre pericoli, quindi un Ascensore deve essere ben installato e ben manutenuto. Con il racconto di un caso d’installazione di un elevatore in un condominio d’epoca a Torino (bocciato dal Tribunale) si mettono in luce i paletti regolatori per garantire un servizio a regola d’arte.
& certificato
Periodico di informazione sul mondo del condominio
Anno 12 - Numero 59 - Ottobre 2024 Direzione, Redazione, Abbonamenti, Amministrazione e Pubblicità
Head office, Editorial office, Subscription, Administration and Advertising
Virginia Gambino Editore S.r.l.
Sede legale: Viale Monte Ceneri, 60 20155 Milano - Italy
Sede operativa: Via San Benedetto, 6 24122 Bergamo - Italy
Tel. +39 02 47761275 condominio@vgambinoeditore.it
Direttore responsabile / Publisher Virginia Gambino / virginia@vgambinoeditore.it
Direttore editoriale
Livia Randaccio /livia@vgambinoeditore.it
Ufficio commerciale - Vendita spazi pubblicitari Commercial department - Sale of advertising spaces Via San Benedetto, 6 - 24122 Bergamo - Italy Tel. +39 02 47761275 - cell. +39 340 1761951 info@vgambinoeditore.it
Collaboratori / Contributors
Rebecca Alberti, Alessandro Bonvicino, Tommaso Brenna, Luca Bridi, Paolo Caliari, Gaia Cicognini, Jessica Collu, Manuel De Stefano, Carlo Pikler, Giuseppe Rossi, Franco Saro, Cristiano Vassanelli
Impaginazione e grafica- Layout and graphics
Raffaella Sesia
Periodicità / Frequency of publication
Bimestrale - sei numeri /anno
Poste Italiane S.p.A. - Spedizione in abbonamento postale - D.L. 353/2003 (conv. in L. 27/02/2004 n.46)art. 1, comma 1 NE/TN
Registrazione / Registration: N. 224 del 2-07-2013 del Tribunale Civile e Penale di Milano Ai sensi del D. Lgs. 196/2003, informiamo che i dati personali vengono utilizzati esclusivamente per l’invio delle pubblicazioni edite da Virginia Gambino Editore Srl. Telefonando o scrivendo alla redazione è possibile esercitare tutti i diritti previsti.
Come abbonarsi / How to subscribe Come abbonarsi / How to subscribe Italia annuo Abbonamento annuo Euro 31,00 Copia singola Euro 8,00 Per abbonarsi è possibile sottoscrivere l’abbonamento online al link:
https://www.virginiagambinoeditore.it oppure, fare richiesta ad abbonamenti@vgambinoeditore.it o telefonando al numero +39 02 47761275
Spedizione in contrassegno
Stampa / Printing
Pixartprinting S.p.A. stabilimento di Lavis (TN)

42 ALUBEL
Obiettivo sicurezza, a partire dalla prevenzione
Emergenza acqua in condominio (ma si può evitare)
Chi deve pagare la tassa sul Superbonus?
Responsabilità / Responsability: la riproduzione delle illustrazioni e articoli pubblicati dalla rivista è riservata e non può avvenire senza espressa autorizzazione della Casa Editrice. I manoscritti e le illustrazioni inviati alla redazione non saranno restituiti, anche se non pubblicati, e la Casa Editrice non si assume responsabilità per il caso che si tratti di esemplari unici. La Casa Editrice non si assume responsabilità per i casi di eventuali errori contenuti negli articoli pubblicati o di errori in cui fosse incorsa nella loro riproduzione sulla rivista.
Efficienza termica e sicurezza sismica
Meno consumi e più protezione con il metallo
58 TRIFLEX
Efficienza e sostenibilità le coperture verdi
48 HOERMANN
Design e confort in sicurezza
50 EUROPAM
Un supporto per le comunità
52
Portale impianti per efficienza e più trasparenza
56 IL RAPPORTO
Più furti in città ma il crimine presenta due facce
60 PRIVACY
Sorveglianza senza limiti ma con limitazioni

Normativa da seguire in saliscendi 72 CEAM
Salita o discesa senza sorprese in ascensore 74 CISA
Niente paura con la porta che dà sicurezza
76 IL TREND
Cresce l'onda della Home Automation
82 WEB
Dati trasparenti e vantaggi palesi in area riservata 86 ACCESSIBILITÀ
Sullo shermo c'è un aiutino
Uno studio formato web ma non solo





Dopo i molteplici casi di legionella, torna in primo piano la necessità di fare prevenzione. Lo stabiliscono le norme ma anche il buonsenso
QAlessandro Bonvicino
uest’anno, in soli quattro mesi, nei comuni tra Corsico e Buccinasco in provincia di Milano, la legionella ha colpito molte persone di cui 56 sono state ospedalizzate. Quattro di queste sono decedute. Basterebbe questo dato per ricordare quanto sia importante tenere sotto controllo gli impianti condominiali, dato che la legionellosi è un’infezione polmonare causata dal batterio Legionella pneumophila, che può annidarsi nelle tubature degli edifici, nei serbatoi, in fontane e piscine. In condominio la legionella può trovare le condizioni ideali per proliferare, le più comuni sono: temperatura dell'ac -
Lo scorso agosto il Comune di Corsico ha emanato un’ordinanza che prevede l’effettuazione tempestiva degli interventi di manutenzione ordinaria e straordinaria nei punti di accumulo condominiali, accompagnata da informazione e sensibilizzazione dei singoli condomini sulla necessità di adottare le misure di controllo e prevenzione anche sui terminali dell’impianto idrico sanitario all’interno delle singole abitazioni. La prevenzione, sottolinea Carlo Dallagiovanna, socio fondatore di Csdm, è un aspetto fondamentale: «Csdm fonda la propria attività sulla prevenzione, con il duplice obiettivo di tutelare e assistere nelle sue funzioni l’amministratore e mettere in sicurezza il condominio, tutelando la salute dei condomini. Si fa prevenzione ottemperando alle prescrizioni di legge. Csdm si avvale di tecnici formati e specializzati per il campionamento dell'acqua in condominio. È fondamentale, infatti, garantire che la campionatura non sia contaminata, non subisca sbalzi di temperatura e venga prelevata in modo consono. Per questo, occorre approntare una serie di accortezze professionali durante le azioni di campionamento che solo tecnici altamente specializzati possono svolgere.
Domanda. I controlli di sorveglianza rappresentano un costo ulteriore per i condomini? Risposta. Ritiene che un costo tra i 4 e i 9 euro per continua a pag.8

segue da pag.7
unità immobiliare possa essere realmente impattante?
Cerchiamo di garantire la massima sicurezza senza essere invasivi nei controlli di sorveglianza. Nei casi in cui si trovasse la legionella occorre mappare l’impianto e supportare l’amministratore di condominio nella gestione degli interventi e nella comunicazione della prassi da seguire ai condomini: l’amministratore deve avvisare i condomini, indicare i comportamenti da tenere nella gestione dell’acqua all’interno degli appartamenti e provvedere alla bonifica dell’impianto. Le statistiche ci dicono che in media quando si bonifica si risolve il problema della legionella. Rimane fondamentale effettuare analisi preventive per monitorare il potenziale innalzarsi dei valori, controllando le situazioni senza dover arrivare alle bonifiche degli impianti, che per i condomini rappresentano un costo oneroso.
D. Sono passati due anni dalla nuova normativa. L’amministratore di condominio ha migliorato le sue conoscenze in fatto di responsabilità e capacità di risposta a un problema così complesso?
R. L’amministratore si trova di fronte a questioni che una volta erano gestite dall’ente pubblico. Csdm si è fatta carico di questa attività e si è organizzata per fornire un servizio di assistenza completa all’amministratore, sia per gli aspetti tecnici che per la parte di comunicazione ai condomini. Una comunicazione sbagliata rischia di creare il panico all’interno del condominio. Al contrario, una buona comunicazione serve a gestire al meglio ogni situazione, sia ordinaria che straordinaria, e a trovare maggior collaborazione da parte di tutte le parti coinvolte.
D. Quante azioni di controllo si fanno in un anno?
R. Sicuramente questo dipende dalla complessità della rete idrica condominiale. La soluzione più economica è un’analisi periodica annuale. Poi, ci sono casi particolari più complessi che possono prevedere anche più campionamenti. Effettuare le verifiche periodiche previste dalla legge significa tutelare amministratori e condomini affrontando un minimo costo e assicurando una prima sorveglianza. La non ottemperanza ai controlli prevede penali che vanno, a seconda dei casi, dai 5 mila ai 30 mila euro mentre il costo dei controlli per i condomini è davvero esiguo.
D. Quale comportamento consiglierebbe a un amministratore?
R. Consiglierei di ottemperare agli obblighi di sorveglianza, di affidare i campionamenti a laboratori certificati che operano con la diligenza e soprattutto con professionisti come Csdm, che hanno l’expertise necessaria a gestire le emergenze ed assisterli sotto
ogni punto di vista.
D. Qual è la percentuale di amministratori che ottemperano?
R. Sul mercato sta accadendo quello che è già successo quando sono state rese obbligatorie le verifiche periodiche degli ascensori e poi degli impianti elettrici. C’è un ciclo di tre-quattro anni in cui il mercato prende coscienza e si adegua. Si mettono in regola prima i grandi centri urbani, e spesso Milano fa da capofila. Poi, la conoscenza e l’azione di prevenzione piano piano si irradia al resto dei territori.
D. Adesso a che punto siamo?
R. Su Milano si è intorno al 70-80%, in provincia sul 50%.
D. Nell’esperienza di Csdm qual è il grado di diffusione della legionella a Milano?
R. Csdm ha statistiche su tutti i codici di avviamento postale di Milano e la diffusione si attesta intorno al 1314% in media, con picchi superiori al 20%. La causa più frequente di legionella è da ricercare nei serbatoi di accumulo. Negli anni i progettisti di impianti per sicurezza hanno spesso sovradimensionato questi serbatoi di accumulo, creando inconsapevolmente più terreno fertile alla legionella. Ma questo è solo uno dei mille aspetti delle problematiche che troviamo nei condomini. Altri aspetti importanti sono i rami morti e molta attenzione deve essere prestata ai boiler dei privati. Anche il boiler, se non correttamente manutenuto, è un luogo di proliferazione del batterio.
D. Csdm che tipo di formazione svolge?
R. Facciamo tanta informazione e formazione agli amministratori di condominio partecipando a simposi e convegni. Uno dei nostri principali punti di forza è lavorare in simbiosi con gli amministratori e i professionisti tecnici. Il nostro servizio di assistenza tecnica è un driver di promozione della cultura della sicurezza nel settore. Siamo consapevoli che un amministratore ben formato trasferisce la cultura della sicurezza ai suoi condomini e introduce correttamente le misure di sicurezza. I social network sono un altro strumento che utilizziamo per diffondere formazione. E devo ammettere che risultano particolarmente pervasivi e quindi utili.
D. L’innovazione tecnologica che negli ultimi anni sta interessando il mondo delle tubazioni che veicolano l’acqua contribuirà ad aumentare la sicurezza?
R. È in arrivo una nuova normativa per certificare i materiali a contatto delle acque destinate al consumo umano che certamente nel lungo periodo migliorerà la sicurezza di tutti noi.
(Rebecca Alberti)
qua calda sanitaria tra i 20 e 50 gradi e accumuli d’acqua che, se non vengono mantenuti in modo corretto, diventano ricettacolo di batteri. E, mentre le autorità sanitarie dell’Agenzia di Tutela della Salute di Milano sono impegnate nell’attuazione di indagini epidemiologiche, microbiologiche e ambientali specifiche, è bene ricordare che seguendo le norme previste si possono evitare drammi umani. Tutto ciò coinvolge anche l’amministratore di condominio nel caso non abbia rispettato le normative sulla prevenzione. Per fortuna esistono anche specialisti in grado di mettere al riparo gli edifici dal pericolo legionella.
IL NUOVO DECRETO
Ma cominciamo dalle regole. Poco più di un anno e mezzo fa è entrato in vigore il decreto legislativo (18/23) che disciplina i parametri minimi per considerare le acque potabili salubri e pulite, a cui sono chiamati a rispondere anche gli amministratori di condominio. Il nuovo decreto ha esplicato meglio alcuni passaggi del precedente provvedimento del 2001 relativi ai parametri necessari per determinare la salubrità delle acque destinate al consumo umano e su chi grava la responsabilità dei controlli. L’obiettivo è garantire la salubrità delle acque destinate al consumo umano. Tra le novità, il provvedimento
comprende nuovi parametri e l’obbligo dell’analisi del parametro della legionella, da verificare insieme agli altri parametri batteriologici. Il decreto, insomma, considera con la giusta importanza la necessità di monitorare questo batterio. Il provvedimento, inoltre, definisce le responsabilità per la gestione dell’acqua, che deve essere garantita nella sua potabilità fino al rubinetto di casa. Per questo motivo c’è l’ente pubblico che si occupa dell’approvvigionamento idrico, che è responsabile fino al contatore, mentre da questo al rubinetto è giurisdizione dell’amministratore.
IL RUOLO DELL’AMMINISTRATORE
L’amministratore, quindi, svolge un ruolo fondamentale: ha l’obbligo di garantire il rispetto dei parametri previsti dalla normativa fino al punto di erogazione dell’acqua, cioè al rubinetto del proprio condomino. Non è un aspetto da sottovalutare: se non rispetta le norme l’amministratore è sanzionabile fino a 30.000 euro. Come deve muoversi, dunque, l’amministratore per rispettare le norme e, non da ultimo, per evitare le sanzioni? Ogni condominio deve attivare una serie di procedure precauzionali, con campionamenti costanti, secondo la dimensione del condominio, affidati a laboratori accreditati e qualificati. È importante, insomma, che chi controlla abbia tutte le

Come si svolgono i controlli per la salubrità dell’acqua? Per un edificio standard, per esempio composto da 28 unità abitative, un singolo campionamento è sufficiente per adempiere al decreto legislativo. Per i condomini più complessi, di volta in volta i tecnici concordano con l’amministratore il numero di campionamenti da effettuare, che possono variare a seconda del numero di scale, delle dimensioni e del numero degli impianti di trattamento acque presenti, come addolcitori o autoclavi. Se il condominio ha più palazzine è
invece necessario verificare le situazioni all’interno dei singoli stabili. Un controllo annuale è sufficiente per garantire un buon livello di sicurezza, senza impattare con costi eccessivi sul condominio. Naturalmente se un condominio nel tempo ha registrato delle criticità è necessario infittire i controlli con un numero maggiore di campionamenti. Tra l’altro, il controllo degli impianti in condominio non riguarda solo l’acqua dei rubinetti, ma coinvolge anche quella di fontanelle e piscine private, seppure queste seguano un’apposita normativa.

carte in regola. Il decreto stabilisce precisamente i nuovi requisiti di salubrità dell’acqua. Per la legionella, per esempio, è stato imposto un limite di accettabilità che per legge è fissato a 1000 Ufc/l (Unità Formante Colonia su litro). Questi parametri devono essere quindi esaminati da laboratori che forniscano anche un alto grado di affidabilità, soprattutto in previsioni di eventuali controlli ATS e cause legali da dover affrontare.
EFFETTO CONTROLLI
Questa precisione è un bene: finora la qualità delle acque negli impianti non è stata delle migliori. Per esempio, le analisi di Csdm indicavano che fino a pochi anni fa la positività al batterio per quanto riguarda Milano interessava il 20% dei campioni, un condominio su cinque. Dati che l’azienda ha trasferito su mappe di rischio. Ora la situazione è migliorata, fino a scendere al 13-14%, proprio grazie ai controlli effettuati, dati che comunque indicano ancora un grosso miglioramento da fare. Proprio la cronaca indica che non è il caso di abbassare la guardia. L’importante, insomma, è che per evitare drammi umani (e le relative sanzioni) i condomini adottino una politica di prevenzione, evitando conseguenze anche fatali per la salute delle persone. D’altra

Da quattro anni Csdm ha iniziato una raccolta sistematica degli esiti dei campioni raccolti nei condomini milanesi. Grazie a un campione statisticamente molto significativo, l’azienda ha realizzato una mappa della legionella, verificando le percentuali per aree definite dai singoli codici di avviamento postale della città. Il risultato del primo anno è stata una grossa sorpresa: oltre alle forti disparità tra i diversi quartieri, probabilmente legate alle vetustà o meno degli edifici, le verifiche hanno mostrato un’alta percentuale di presenza del batterio in alcune zone, dove negli anni scorsi era arrivato a interessare oltre il 20% dei condomini. Le analisi sono state sempre condotte rispettando criteri molto rigorosi. Oltre a una importante preparazione a monte, l’azienda si affida a uno dei migliori laboratori di analisi in Italia certificato Accredia, dal ministero della Salute, dalla Regione Piemonte e Lombardia. Il campionamento segue rigide procedure affidate a personale dipendente e formato, che garantisce sicurezza a tutta la filiera, dal momento in cui entra in condominio fino a quando perviene il certificato dal laboratorio. L’iniziativa dell’azienda ha sollevato un grosso interesse da parte della comunità professionale e questo ha dato forza anche ai singoli amministratori nel portare avanti queste iniziative di fronte ai condomini. Il fatto di avere una mappa della legionella che dimostrava lo stato di fatto quartiere per quartiere ha giustificato l’operato dell’amministratore.
parte, è lo stesso buonsenso che ha ispirato normative come quelle sugli ascensori o i cancelli automatici: i controlli regolari hanno ridotto al minimo gli incidenti.
NON SOLO BATTERI
I pericoli per gli impianti idrici, tra l’altro, non si possono limitare alla legionella: un altro rischio riguarda sostanze che possono essere nocive. La normativa si occupa anche di questo: con il nuovo decreto sono stati introdotti i Pfas, Pfoa, l’uranio e i composti aleoacetici, che devono essere controllati nel percorso dell’acqua prima che arrivi al contatore. Inoltre, va controllata la eventuale quantità di piombo, o di altri batteri come i coliformi all’interno della rete idrica condominiale.
Anche i condomini sono correttamente avvertiti dell’eventuale pericolo: Csdm mette a disposizione una serie di informazioni condivise con gli abitanti del condominio in merito a procedure da seguire per la bonifica o la verifica dei campioni. Soprattutto nel caso della legionella, l’azienda si






preoccupa di inviare un decalogo di comportamenti da tenere. La sicurezza, per esempio, non comporta evitare di utilizzare la cucina o il bagno: in realtà la legionella è pericolosa solo inalata, magari facendosi la doccia. Diverso il caso di colonie batteriche coliformi: in quel caso è vietato bere l’acqua del rubinetto. Una volta eseguite le analisi viene rilasciato un certificato firmato da un professionista, con un riferimento al laboratorio che ha accreditato le analisi e a tutte le specifiche della richiesta del decreto legislativo. Insomma, quali iniziative deve intraprendere un ammini- stratore per assicurarsi che la rete idrica sia salubre? Per mettersi al riparo da epidemie di legionella un ammini- stratore dovrebbe affidare il controllo e la sorveglianza periodica a società rigorose. Csdm, per esempio, può ga- rantire la dovuta attuazione delle procedure per dare cer- tezza di risultati certificati. Il decreto ministeriale indica espressamente che le analisi devono essere sottoposte a regime di accreditamento Uni Cei En Iso/Iec 17025 e affidate solo a laboratori certificati.

Il governo ha introdotto un’imposta aggiuntiva per chi vende l’abitazione, anche condominiale, dove sono stati eseguiti lavori con il 110%. Ma l’applicazione rischia di far venire il mal di testa. Ecco quando si applica
























Aumenta il numero di impianti fotovoltaici, sempre più utenti prevedono di trasformarsi in autoproduttori. E da aprile sono diventate operative le Cer: si registra già un boom di richieste




L’intervento di efficientamento e miglioramento dell’involucro del condominio XXV Aprile ad Ascoli Piceno, che ha beneficiato degli incentivi del Superbonus 110%, ha consentito un salto energetico di 5 classi. Per l’isolamento ventilato delle ampie superfici delle facciate è stato posato il sistema Isotec Parete Black

a



1.
2.
3.
8.
4.
5.


7







Difficoltà nella produzione di energia pulita a causa dell’ostilità a parchi eolici e fotovoltaici. Incognite per l’auto elettrica. Così la soluzione più semplice sono gli edifici autonomi che generano corrente







● Casetta per attrezzi Berry Classic con tetto a due spioventi in grigio finestra RAL 7040
● Montaggio semplice e rapido grazie al massimo grado di prefabbricazione
● Le nostre soluzioni sono il risultato di un ciclo produttivo a emissioni zero di CO2, risultato ottenuto grazie ad attività di calcolo, riduzione e compensazione delle emissioni di anidride carbonica
Per maggiori informazioni sulla nostra strategia di sostenibilità, visitate il sito www.hoermann.com/sustainability
www.hormann.it
info@hormann.it

Una corretta tecnica per coperture areate consente di ridurre i consumi grazie a un isolamento più efficiente, oltre a renderle più durature e resistenti







Esempio di posa a festoni dello schermo traspirante








Per la nuova copertura di un’azienda veneta sono state utilizzate lastre in alluminio di diversi profili e dimensioni per garantire le più elevate prestazioni
Innovare un edificio e renderlo più efficiente da un punto di vista energetico: è quanto avvenuto per Starcolor, un’azienda che si occupa di verniciature industriali a polveri, con sede a San Donà di Piave (Venezia), una zona caratterizzata da una forte concentrazione di attività produttive, dinamiche e operose. La necessità di ampliare la sede aziendale è stata l’occasione per il suo completo rinnovamento: oltre ai nuovi locali di deposito e

corpo uffici (totale 450 metri quadrati), costruito ex novo con struttura in acciaio e pareti con pannelli metallici coibentati e contropareti in cartongesso, è stato infatti sostituito il manto di copertura in lastre di eternit (2.200 metri quadrati).
DIVERSI COLORI
Tutti i nuovi rivestimenti sono firmati Alubel: per la nuova copertura lastre AZ 185 profilo Alubel 28 e lastre rette grecate in lamiera profilo Alubel 40, per le pareti del nuovo ampliamento lastre Ond-All 33 in alluminio anodizzato, Easy Wand colore bianco puro Ral 9010 e grigio antracite Ral 7016. Alternando le diverse colorazioni e le tipologie di lastra, il progettista, l’architetto junior Gianni Granzotto dello studio Granzotto Associati, ha realizzato un edificio elegante e dalla forte riconoscibilità, che ben si distingue dal contesto. Inoltre, grazie all’utilizzo dei rivestimenti metallici Alubel sono garantite la massima protezione all’acqua, elevate prestazioni termiche, la notevole durabilità e la completa riciclabilità.
La posa è stata effettuata dalla Tecnoinfissi di Eraclea (Venezia), che grazie anche alla proficua collaborazione con i referenti Alubel, ha completato le lavorazioni con la massima efficienza.

Sistemi di impermeabilizzazione
applicati in tutta Europa per realizzare coperture condominiali durevoli, che contribuiscono al comfort e al risparmio energetico e che resistono alle manifestazioni atmosferiche estreme
Le coperture degli edifici sono un elemento chiave per l’efficienza e la sostenibilità dell’edificio. Triflex, azienda che opera nel settore delle soluzioni d’impermeabilizzazione liquide a base di Pmma, fornisce sistemi per l’impermeabilizzazione, specifici per tetti a ritenzione idrica, tetti piani chiari e tetti verdi. Scopriamone prestazioni e applicazioni.





L’utilizzo di vegetazione e i dispositivi di accumulo dell’acqua nei tetti a ritenzione idrica richiedono una particolare progettazione e realizzazione dell’impermeabilizzazione sottostante, che può essere realizzata con i sistemi di impermeabilizzazione liquidi di Triflex a base di Pmma, certificati per la resistenza a radici e rizomi e in grado di impermeabilizzare le superfici senza giunti, anche in presenza di dettagli e forme architettoniche complesse. I tetti a ritenzione idrica possono essere realizzati in diverse modalità:
• con l’utilizzo di vegetazione;
• installando strati di ritenzione e infiltrazione in materiali speciali che immagazzinano l’acqua e consentono il deflusso graduale;
• prevedendo vasche o cisterne da posizionare sul tetto o nelle vicinanze per raccogliere l’acqua piovana. Il deflusso dell’acqua piovana si riduce del 58% con il verde estensivo e fino al 79% con il verde intensivo. Le riduzioni possono essere anche maggiori se vengono adottate precauzioni tecniche per limitare i deflussi o se vengono creati ulteriori spazi di stoccaggio. Se i tetti a ritenzione idrica, detti anche tetti di contenimento, sono dotati anche di recupero dell’acqua, l’acqua piovana raccolta può essere trattenuta anche per mesi con scarse precipitazioni o riutilizzata per vari scopi, ad esem-
pio, per irrigare le aree verdi o per alimentare lo sciacquone dei wc, riducendo così il consumo di acqua dolce. Questi tetti contribuiscono a migliorare il microclima, favoriscono l’habitat per piante e insetti e abbassano la temperatura ambientale nelle aree urbane, contrastando le isole di calore. Optare per questa tipologia di tetto, nel caso dei condomini, significa garantire maggiore comfort, efficienza energetica e di consumo idrico e un contributo positivo al microclima e all’ambiente. Le soluzioni Triflex, in quanto specifiche per queste applicazioni, sono durevoli e a bassa manutenzione.
I TETTI PIANI
CON FINITURE CHIARE RIFLETTENTI
Nel fabbisogno energetico globale di un edificio si possono raggiungere risparmi consistenti con la realizzazione di una copertura riflettente bianca del tetto piano, che può essere realizzata con Triflex ProSolar, il sistema di impermeabilizzazione liquido a base di Pmma di Triflex. Triflex ProSolar consente di:
• riflettere la luce solare in modo più efficace rispetto a qualsiasi altro colore;
• ridurre la temperatura media all’interno dell’edificio, diminuendo la necessità di impiego di condizionatori d’aria con un notevole vantaggio economico e ambientale;
• ottenere una temperatura superficiale di 40°C e una
Giardino pensile hotel St. Gallen in Svizzera. Sotto, tetto verde Deutsche Bundesbank a Monaco. Entrambi impermeabilizzati con sistemi Triflex

temperatura media interna all’edificio di 25°C, di molto inferiore rispetto a quella degli edifici con rivestimento del tetto in colore nero (valori medi 80°C esterni e 30°C interni);
• in caso di installazione di pannelli fotovoltaici, migliorare le prestazioni dell’impianto e facilitare la manutenzione della superficie.
TETTI VERDI
ALLEATI DELLA SOSTENIBILITÀ
I tetti verdi sono sempre più apprezzati, ma presentano la difficoltà di realizzare un’impermeabilizzazione che resista anche ad aggressioni particolari, quali quelle di radici e rizomi.
I sistemi Triflex si contraddistinguono per la loro resistenza alle radici e rizomi e per la loro capacità di impermeabilizzazione ottimale e duratura, anche in caso di ristrutturazione di tetti danneggiati con infiltrazioni. Vengono applicati a freddo e sono compatibili con quasi tutte le superfici più comuni, alle quali aderiscono perfettamente, grazie alla loro forma liquida. In virtù delle loro caratteristiche, possono essere posati anche con temperature sotto lo zero. Il sistema liquido Triflex ProDetail consente di impermeabilizzare in maniera ottimale e duratura anche dettagli costruttivi complessi. Nel caso del centro culturale Gasteig di Monaco,

l’impermeabilizzazione del tetto è stata eseguita applicando i sistemi liquidi di Triflex direttamente sulle guaine bituminose esistenti senza bisogno di essere smantellate, risparmiando denaro e tempo e, grazie all’applicabilità dei sistemi Triflex a freddo, senza rischi dovuti all’utilizzo di fiamme ossidriche in presenza di impianti elettrici.
HÖRMANN
La nuova porta d’ingresso
ThermoCarbon presenta
una soluzione di serie in classe RC 3, disponibile a richiesta anche con equipaggiamento Rc 4. Alta resistenza, ma anche motorizzazione hi-tech e basso impatto ambientale
Confort, design, sicurezza ed efficienza energetica. Quattro caratteristiche che servono a definire la nuova porta d’ingresso ThermoCarbon di Hörmann. L’azienda specializzata in chiusura presenta una soluzione di serie in classe Rc 3, disponibile a richiesta anche con equipaggiamento di sicurezza Rc 4. La porta, inoltre, garantisce prestazioni energetiche al vertice di categoria assieme a un design particolarmente curato.


La porta d’ingresso ThermoCarbon rappresenta il vertice assoluto della gamma proposta da Hörmann, frutto di investimenti in ricerca & sviluppo sulla base delle esigenze emerse sul mercato a livello mondiale. La classe di sicurezza Rc 3 permette di contrastare malintenzionati che provino a forzare la porta chiusa a chiave con arnesi come un piede di porco o semplici utensili di perforazione, per un periodo di massimo 5 minuti. A richiesta, però, ThermoCarbon è disponibile anche con equipaggiamento di sicurezza Rc 4 , in grado di bloccare uno scassinatore esperto che tenti di aprire la porta chiusa a chiave con arnesi, come un piede di porco o utensili di perforazione e urto, per un periodo di massimo dieci minuti. Sempre per maggiore sicurezza, il modello presenta un bloccaggio a nove punti di serie e cerniere occultate antiscardinamento, capaci di garantire un’elevata tranquillità nel caso di un tentativo di scasso. Anche eventuali finestrature assicurano il più alto livello di safety e security: sono realizzate in vetro stratificato antischegge, spesso 8 millimetri che, in caso di rottura, trattiene le schegge in una speciale pellicola interna, proteggendo persone, arredi e oggetti nell’area antistante la chiusura, sia all’interno che all’esterno dell’abitazione.
ALLUMINIO E CARBONIO
Realizzata in alluminio e carbonio, materiali in costruzione leggera, ThermoCarbon può in più incrementare significativamente il valore energetico dell’immobile: presenta un valore di trasmittanza termica fino a 0,47 W/(m²xK) e risulta una soluzione non solo per edifici
residenziali che mirino a un ottimale comfort termico, ma addirittura per le case passive e a bilancio energetico positivo che producono più energia di quanta ne utilizzino. L’elevato isolamento è reso possibile dal battente in alluminio a filo della superficie spesso 100 millimetri, dotato di un pannello di riempimento in schiuma rigida in poliuretano a piena superficie e di un profilo composito alloggiato all’interno.
ISOLAMENTO ACUSTICO
Soluzione tecnologicamente avanzata, la porta è all’avanguardia anche in termini di comfort: può essere infatti non solo dotata di motorizzazione con tecnologia BiSecur, un sistema che utilizza una codifica estremamente sicura, Aes 128, impiegata, per esempio, per l’online banking. Ma può anche essere aperta in modo smart, tramite inserimento di codice, lettore di impronte digitali o smartphone.
Dal punto di vista del design, ThermoCarbon è disponibile in 21 motivi e in 23 colori preferenziali. Su richiesta, è inoltre possibile scegliere tra 200 colori Ral, oppure optare per un modello bicolor o, ancora, per una soluzione che presenti un diverso colore, all’esterno e all’interno. Il portoncino può anche essere configurato sul sito dell’azienda e presenta un elevato isolamento acustico (fino a 32 dB). Ha una garanzia di dieci anni ed è, come tutti i prodotti Hörmann, oggetto di un ciclo produttivo impostato su severi criteri ecologici. Tra le altre iniziative a tutela del pianeta, l’azienda copre il suo fabbisogno energetico al 100% con elettricità verde, riducendo di migliaia di tonnellate le emissioni di CO 2.
Direttive Ue e leggi italiane incentivano il risparmio dei consumi, anche con la produzione di elettricità. Più semplice con l’aiuto e le soluzioni degli esperti dell’azienda
IFranco Saro
l risparmio energetico rappresenta oggi una delle questioni più rilevanti sia a livello internazionale che locale, in considerazione dei crescenti problemi legati ai cambiamenti climatici e all’aumento dei costi energetici. Oltre agli accordi internazionali, come l’Accordo di Parigi del 2015, che ha fissato ambiziosi obiettivi per limitare l’aumento della temperatura globale, molte nazioni stanno introducendo misure normative per promuovere l’efficienza energetica, sostenendo tecnologie che riducono il consumo energetico, come edifici a basso impatto, apparecchiature a elevata efficienza e mobilità sostenibile. In Italia, il Piano Nazionale Integrato per l’Energia e il Clima (Pniec) rappresenta uno degli strumenti principali per promuovere una transizione energetica sostenibile, puntando ad una riduzione significativa delle emissioni di gas serra entro il 2030.


Le comunità energetiche si configurano come una delle soluzioni più innovative e inclusive per affrontare la sfida energetica e promuovere l’uso di fonti rinnovabili, rappresentando un nuovo modello di produzione e consumo in cui cittadini, imprese e istituzioni locali collaborano per produrre, condividere e consumare energia da fonti rinnovabili. Il principio alla base è la condivisione dell’energia prodotta localmente, permettendo di ridurre così la dipendenza dalla rete nazionale e favorendo un’economia circolare dell’energia. L’approccio incentiva la partecipazione attiva dei cittadini, che non sono più solo consumatori passivi di energia, ma diventano prosumer, ovvero produttori e consumatori allo stesso tempo.
La normativa italiana ha recepito la direttiva Europea Red II (Renewable Energy Directive), che stabilisce il quadro normativo per il sostegno alle energie rinnovabili e ha introdotto una serie di incentivi per favorire la costituzione di comunità energetiche. In particolare, la legge di Bilancio 2020 ha segnato un punto di svolta per la loro regolamentazione, introducendo il concetto di autoconsumo collettivo e prevedendo la possibilità per cittadini, imprese e amministrazioni pubbliche di costituire Comunità energetiche rinnovabili. Nel 2024, il panorama delle comunità energetiche in Italia è in forte espansione. La crescente consapevolezza ambientale, unita alla volontà di ridurre i costi energetici, hanno portato alla nascita di progetti che trovano applicazione in contesti urbani e rurali, con un particolare interesse per le aree periferiche o montane, dove l’autosufficienza energetica può rappresentare una risorsa fondamentale per contrastare lo spopolamento e rilanciare l’economia locale.

Europam, azienda leader nel settore energetico, gioca un ruolo cruciale nello sviluppo delle comunità energetiche in Italia. Con anni di esperienza nel settore dell’energia, offre consulenza e supporto tecnico per la realizzazione di comunità energetiche, fornendo soluzioni personalizzate a privati e aziende, con l’obiettivo di massimizzare i benefici sia economici che ambientali. Europam si impegna non solo a fornire le infrastrutture necessarie, come impianti fotovoltaici o sistemi di accumulo, ma anche a facilitare l’accesso agli incentivi previsti dalle normative nazionali ed europee, accompagnando i partecipanti in tutte le fasi del progetto, dalla progettazione alla gestione operativa. Nel 2024, l’Italia è al centro di una rivoluzione energetica che vede nelle comunità energetiche una delle soluzioni più promettenti per un futuro a basse emissioni. Grazie all’impegno dei diversi players del settore, questo modello si sta diffondendo offrendo a cittadini, imprese e pubbliche amministrazioni l’opportunità di diventare protagonisti attivi nel processo di transizione energetica, contribuendo al raggiungimento degli obiettivi climatici fissati dall’Unione Europea per il 2050.
I servizi offerti via web trasformano la complessità della ripartizione e delle contabilizzazioni in un vantaggio sensibile per i gestori e gli amministratori
CFranco Saro
onoscere per tempo informazioni dettagliate sui consumi permette non solo di ottimizzare il funzionamento degli impianti, ma anche di gestirli al meglio, generando risparmi per gli utenti, per gli amministratori di condominio e i gestori delle strutture. Un aspetto su cui è focalizzata ista Portale Impianti, una piattaforma di servizi evoluti, allineata con gli obiettivi dell’ultima direttiva

europea sull’efficienza energetica (Eed), recepita dal governo attraverso il decreto legislativo 73/2020 in materia di comunicazione delle letture dei consumi dei singoli utenti. Il monitoraggio quotidiano dei dati di contatori e ripartitori di calore installati nei condomìni avviene in modalità remota nella massima accuratezza, trasparenza e riservatezza.
INFORMAZIONI SEMPLICI
I dati, accessibili via web, sono organizzati in informazioni semplici e chiare e agevolano la consultazione dei consumi per riscaldamento, raffrescamento e acqua potabile: ista Portale Impianti è uno strumento pratico, completo ed efficiente per minimizzare le incombenze amministrative, liberando tempo prezioso per il professionista da dedicare ad attività con maggiore valore aggiunto.
Tutti i dati per gestire al meglio l’attività, macro e micro, sono mantenuti in archivio su ista Portale Impianti e sono completamente consultabili tramite pc, tablet e smartphone da parte dei gestori e degli amministratori di condominio. La piattaforma consente di consultare la panoramica di tutti gli immobili, delle unità abitative e del rispettivo consumo energetico complessivo, avere sotto controllo la struttura di ogni singolo impianto, con un elenco dettagliato di tutti i dispositivi installati in ogni unità immobiliare e collegati via radio al portale, con possibilità di inserire i subentri per emettere sempre bollette precise e aggiornate e visualizzare graficamente il consumo dei singoli utenti, e per ciascun dispositivo con archiviazione dei dati fino ai 36 mesi precedenti.
ALTRI VANTAGGI
Non solo: nel caso in cui sia necessario gestire più condomìni con il portale, può attivare un utente secondario da una sezione dedicata da cui affidare ogni singolo impianto a un diverso utente, fornendo ad ognuno credenziali dedicate per la visualizzazione e la gestione dei dati di consumo del proprio impianto, filtrare e scaricare i conteggi effettuati e i report di lettura (che possono essere giornalieri o mensili), nei diversi formati, compreso il formato .xml per i report lettura, per una facile consultazione e archiviazione, ricevere notifiche rispetto ad anomalie nel funzionamento dei dispositivi che potrebbero portare a eventuali mancate letture e a conseguenti ripartizioni effettuate su base di una stima del consumo.
NOTIFICHE
Infine, il portale consente di ricevere




notifiche relative al servizio ricerca perdite acqua: l’utente riceverà una notifica se si registrano perdite rilevate dai dispositivi installati, e di richiedere interventi di assistenza, manutenzione e riparazione, con possibilità di monitorarne lo stato attraverso il portale senza la necessità di utilizzare telefono o e-mail. Così ista Portale Impianti trasforma i dati delle letture dei consumi in benefici operativi per amministratori e gestori, a fronte del minimo impegno di risorse professionali e con la certezza di un costante aggiornamento, in termini di evoluzione delle normative e di innovazione tecnologica dell’intero sistema. Assieme a ista Connect, il portale dedicato agli utenti, che mette a disposizione tutte le informazioni circa i propri consumi in modo preciso, aggiornato e dettagliato, ista Portale impianti risponde a tutti i requisiti previsti dalla Eed e offre un pacchetto di servizi per gestire gli impianti condominiali, a vantaggio di una maggiore efficienza energetica,
Essere informati in tempo reale circa condizioni di allerta connesse al funzionamento dell’impianto significa prevenire disagi e perdite di tempo: per questo ista Italia aggiunge la nuova sezione Alert System a ista Portale Impianti. È una nuova funzionalità del Portale Impianti dedicata all’allerta proattiva per informare in tempo reale gli operatori in merito a eventuali condizioni critiche connesse al funzionamento dell’impianto, prevenendo eventuali interruzioni dei servizi e gli eventuali costi conseguenti.
L’applicazione monitora lo stato dei dispositivi collegati alla rete Symphonic Sensor Net, integrandosi perfettamente con tutte le altre funzioni e consente di programmare velocemente interventi di manutenzione preventiva evitando qualsiasi malfunzionamento. In caso di anomalie, segnalazioni di errore, infatti, Alert System di ista Italia invia sia delle e-mail alla casella predefinita, sia delle notifiche direttamente su Portale Impianti, al fine di consentire l’immediata attivazione del servizio di assistenza, limitando al massimo spiacevoli sorprese e costi non programmati.
Alert System di ista Italia sarà in grado di rilevare e segnalare, nell’arco di quaranta giorni, anche l’eventuale assenza di trasmissione da parte dei dispositivi al sistema di lettura remota, evitando così la mancata lettura a fine stagione. In sede di ripartizione dei costi di riscaldamento o di fornitura dell’acqua, infatti, la mancata lettura comporta l’assenza dei dati del consumo effettivo di uno o più utenti e porta normalmente alla necessità di stimare a posteriori il consumo individuale con perdite di tempo non programmate: Alert System di ista Italia elimina questa eventualità, a vantaggio dell’attività degli operatori professionali informando amministratori e gestori prima che il malfunzionamento si verifichi.
La notifica/e-mail, inviata dal sistema a una o più caselle di posta predefinite, può contenere tutte le informazioni utili per individuare il dispositivo e aprire una richiesta di assistenza, e consente di individuare nel dettaglio le cause, procedendo con il ripristino immediato delle funzionalità o, se necessario, alla sostituzione di uno o più dispositivi.
Basato sull’avanzata tecnologia dei sistemi SoC a
per risparmiare risorse e denaro, per una maggiore consapevolezza dei propri consumi e per proteggere il clima. «Il mondo della contabilizzazione e del risparmio energetico è in rapida evoluzione e i nostri clienti hanno bisogno costantemente di essere stimolati con soluzioni chiare, semplici e puntuali per definire le loro strategie

radiotrasmissione, l’accurato servizio di monitoraggio e segnalazione di Alert System di ista Italia è un’applicazione già disponibile, attivabile negli impianti dotati di un concentratore di dati Amm, previa verifica della copertura del segnale Gsm/Gprs/Lte della zona di ubicazione dell’impianto. Il processo di attivazione è semplice e lineare e si svolge nell’arco di poche settimane, in accordo con quanto prescritto nella documentazione tecnica e con il supporto del team di ista Italia.
Ecco come si procede: prima l’installazione, programmazione e attivazione dei dispositivi (contatori, contabilizzatori, concentratori, ecc.) nell’edificio, poi raccolta e invio delle mappature dei dispositivi installati, per l’inserimento dei dati in ista Cloud System.
Una volta attivato il servizio Alert System di ista Italia, il professionista, attraverso ista Portale Impianti potrà configurare rapidamente il servizio secondo le proprie esigenze, selezionando i dispositivi da monitorare, attivando le notifiche e scegliendo gli indirizzi e-mail a cui far inviare le allerte dal sistema.
Concepito per supportare e semplificare l’attività degli operatori professionali, il servizio di allerte proattive Alert System di ista Italia costituisce un significativo vantaggio anche per gli utenti, che usufruiranno sempre di una corretta ripartizione delle spese e della trasparenza delle relazioni con gli operatori professionali, garantiti dall’esperienza e dalla competenza di ista Italia fornitore di servizi evoluti a vantaggio del risparmio energetico e del benessere ambientale.
e i programmi di crescita e per questo servono professionisti che siano, innanzi tutto, competenti e che abbiano grande entusiasmo», commenta Massimiliano Artese Direttore Commerciale di ista Italia. «Innovazione, tecnologia, capacità di ascolto e risposte accurate sono i punti cardinali della nostra azienda».




Milano al primo posto per denunce di reati, seguita da Roma. Cresce il tasso di violenza e rapine, ma siamo lontani dal record raggiunto dieci anni fa: nei primi sei mesi del 2024 i reati sono diminuiti
Giuseppe Rossi





L’Authority ai dati personali ha stabilito che una videocamera di sicurezza può inquadrare anche una parte di area pubblica solo a patto che siano rispettate alcune salvaguardie







Nasce il nuovo cilindro CISA RS5, con tecnologia radiale di ultima generazione e duplica digitalizzata per offrirti tutta la protezione di cui hai bisogno, sempre a portata di mano.
cisa.com allegion.com
Il cilindro brevettato a 5 file di perni radiali in acciaio carbonitrurato è il punto di arrivo dell’esperienza trentennale di CISA nello sviluppo di cilindri di massima sicurezza.
Il caso dell’installazione di un elevatore in un condominio d’epoca a Torino (bocciato dal Tribunale) mette in luce i paletti regolatori per un servizio in completa sicurezza





Sorprese in bolletta? No, grazie.
Il futuro della gestione condominiale per la ripartizione e contabilizzazione dell’energia è qui: con notifiche tempestive di eventuali anomalie, risparmi tempo e denaro!

Con Europam risparmi tempo, spese ed energia. Scopri come massimizzare i consumi e ridurre gli sprechi su europam.it
info@europam.it





Nuova edizione nell’era del superbonus: nuove schede, nuovi suggerimenti, nuovi commenti: l’edizione 2023 della Guida ha sempre il comodo formato tascabile (cm. 15 X 21) e rappresenta un indispensabile strumento di consultazione sulle novità normative, su tutti gli incentivi fiscali e, attraverso schede sintetiche, fornisce informazioni sui principali interventi per l’efficientamento e la manutenzione dei condomini.
COMPRA LA TUA COPIA € 9,00

Attraverso l’esclusivo contributo di importanti esperti, la Guida affronta i problemi del condominio partendo dalle soluzioni tecnicamente ed economicamente più valide per migliorare la qualità della vita nei condomini. L’abbonamento a CONDOMINIO Sostenibile e Certificato comprende anche l’edizione digitale per sfogliare in anteprima tutto quanto c’è di più nuovo nel mercato e avere sempre a portata di clic la rivista.
1 anno
4 numeri
€ 31,00 anziché € 39,00
Tecniche, verifiche, normative: il puzzle da comporre per ottenere la massima sicurezza (e comfort) per i condòmini che usano un elevatore
Franco Saro
Il condominio è un ambiente familiare, con cui abbiamo confidenza, ma sottotraccia è anche un sistema articolato, formato da diversi complessi tecnologici, come linee elettriche, tubature idrauliche che ne supportano la sicurezza, per chi lo abita. Come un puzzle è formato da tante tessere, che insieme compongono il quadro finale. Dei vari sistemi fa parte anche l’ascensore che, come ogni altro componente, deve essere sicuro e affidabile. Ma cosa determina la sicurezza di un ascensore? Sicuramente possiamo identificare due grandi tematiche: deve essere sicuro dal punto di vista tecnico impiantistico e affidabile per l’uso da parte dell’utenza.
INSTALLAZIONE E COLLAUDO
Sicurezza tecnica. Comprende tutto ciò che riguarda l’ascensore e la sua installazione, in quanto macchina. La verifica dei requisiti di sicurezza dell’installazione inizia con il collaudo al temine della collocazione e prosegue con la manutenzione e le verifiche ordinarie. Solo il collaudo positivo permette, infatti, l’apertura al pubblico l’elevatore. Durante il collaudo si verifica che la progettazione e l’installazione stessa siano conformi alle norme vigenti e che la realizzazione sia a regola d’arte. Questo

collaudo non interessa unicamente l’ascensore in sé, ma anche l’ambiente e i locali coinvolti per il funzionamento del sistema, come la presenza di una rete anti volatili nel vano di areazio ne, per evitare la presenza di alati all’interno dell’edificio, che potrebbero rendere insalubre il vano dell’ascensore sia per gli utenti, che per il personale tecnico che periodicamente effettua controlli e manutenzione. Oppure, la rispondenza alle norma tive del locale macchina e del percorso per raggiungerlo, con l’applicazione di porta antipanico per le emergenze, oppure una illuminazione adeguata a identificare gli ostacoli con facilità. Dopo il collaudo dell’ascensore occorre garantire che la sicu rezza certificata sia garantita nel tempo. Tale verifica è affidata


viste periodiche, ne conferma lo stato di adeguatezza ed even tualmente, segnala al condominio la necessità d’eseguire la sostituzione di componenti usurati o danneggiati. Questa prassi è analoga a quella che applichiamo alla manutenzione delle automobili, per le quali, i tagliandi ci mettono nelle condizioni di mantenere il veicolo sicuro, e ridurre al minimo la possibilità che la vettura si fermi o non risponda correttamente alla nostra giuda e possa causare incidenti.
UTILIZZO PRATICO
Sicurezza d’uso. Si riferisce all’interazione tra i passeggeri e l’ascensore, sia in condizioni di normale utilizzo, sia in condizioni d’emergenza. L’esempio più intuitivo è quello del dislivello che talvolta esiste tra il piano di sbarco del pianerottolo e il pavimento della cabina. Questo dislivello è generalmente dovuto alla tecnologia usata al momento della progettazione dell’elevatore. Il gradino, che potrebbe crearsi, costituisce un rischio di inciampo, in entrata o uscita dalla cabina e, potenzialmente, potrebbe essere cause di infortuni di varia entità. Per evitarlo, i moderni ascensori dispongono di sistemi che limitano questo dislivello a pochissimi millimetri, o lo eliminano del tutto. Mentre, gli ascensori più vetusti possono essere modernizzati con apparecchiature che gestiscono questo gradino, fino ad eliminarlo.
Un altro esempio di elemento di sicurezza per l’utente è la presenza in cabina di un dispositivo di chiamata che, in caso di blocco, metta in contatto diretto il passeggero con un centro d’assistenza. Qualora il dispositivo sia anche dotato di display, questo contatto può avvenire in videochiamata, facilitando la gestione della situazione e rendendo più confortevole e rassicurante questa situazione critica: una enorme differenza rispetto al vecchio campanello d’allarme, che suonava solo nel vano scale del condominio e lasciava il passeggero in balia del buon udito e della presenza di altre persone nell’edificio.
La sicurezza in condominio coinvolge anche l’ascensore. È importante che siano presi in considerazione molteplici fattori, da valutare attentamente per consentire a tutti di muoversi dentro e fuori dall’edificio in modo accessibile, sicuro e semplice.

Nei locali in cui
sono previsti meccanismi
antipanico, cisa Multitop
Matic Exit si propone come soluzione che elimina ogni rischio. E può anche essere gestita da remoto
Franco Saro
La porta con dispositivo antipanico è obbligatoria in molti contesti edilizi, come attività commerciali, luoghi di lavoro, ma anche edifici di residenza pubblici e privati, dove si trovano locali che possono ospitare oltre nove persone assieme (e in misura diversa secondo la location). Cisa
Multitop Matic Exit è una soluzione di sicurezza per porte antipanico a una o due ante. Offre una combinazione ottimale tra protezione antintrusione e sicurezza rapida in caso di emergenza. Il suo sistema automatico con non solo rende le uscite sicure e sempre pronte all’uso, ma aggiunge un livello di efficienza che semplifica la gestione quotidiana.


CHIUSURA AUTOMATICA
Con Multitop Matic Exit, la sicurezza diventa un processo automatico. Le porte si chiudono da sole in sicurezza, senza bisogno di chiavi o interventi manuali. Avvicinando l’anta principale al montante, i tre scrocchi e i ganci entrano immediatamente in azione, garantendo sei punti di chiusura. Una soluzione che elimina il rischio di porte lasciate aperte, rendendo l’ambiente sicuro in ogni momento. Per le porte a doppia anta, il sistema, composto da controserratura automatica a testata lunga e riarmo automatico, assicura anche la chiusura sicura dell’anta secondaria, offrendo protezione completa senza compromessi.
APERTURA IMMEDIATA
In emergenza, ogni istante conta. Multitop Matic Exit consente di aprire le porte rapidamente con un semplice gesto, premendo la barra del maniglione. Questo meccanismo di rilascio rapido è essenziale per garantire un’evacuazione sicura e senza ostacoli. In caso di incendi o altre emergenze, sapere che le uscite sono sempre pronte e funzionanti riduce il rischio per tutti gli occupanti.
CONTROLLO ACCESSI INTELLIGENTE
La tecnologia avanzata e integrata con il Motore Cisa offre la possibilità di gestire l’apertura delle porte da remoto. Il sistema è compatibile con una vasta gamma di credenziali: citofoni, tastiere, transponder, smartphone e altro ancora. Questa

flessibilità permette ai gestori di controllare in tempo reale chi accede agli spazi, rendendo il monitoraggio centralizzato e più efficiente.
INSTALLAZIONE FACILE E VELOCE
Un altro vantaggio del sistema Cisa Multitop Matic Exit è la sua semplicità di installazione. Grazie alle bocchette regolabili integrate e al sistema di regolazione dei puntali, l’installazione è rapida e senza complicazioni. Che si tratti di nuove costruzioni o di aggiornamenti su porte esistenti, il sistema si adatta facilmente, riducendo i tempi di fermo e i costi di installazione. Una soluzione che semplifica la vita, senza necessità di modifiche strutturali complesse.
COMPATIBILITÀ
La retrocompatibilità con i sistemi preesistenti, come Sikur Exit, rende Multitop Matic Exit una scelta ancora più versatile. Per chi ha già in uso soluzioni di sicurezza Cisa, l’aggiornamento è semplice e senza interventi aggiuntivi significativi. Si può quindi migliorare la sicurezza, senza dover affrontare lavori costosi e invasivi.
Con le sue funzionalità avanzate, Cisa Multitop Matic Exit è una risposta per chi cerca un sistema di sicurezza intelligente, pratico e sicuro. La combinazione tra chiusura automatica, apertura rapida in caso di emergenza, controllo accessi remoto e facilità di installazione lo rende un prodotto versatile nei contesti residenziali.
Aumenta il numero di italiani che installa nella propria abitazione dispositivi digitali. Il nuovo sistema Matter facilita la compatibilità e la diffusione delle funzionalità. Ma spesso il modo di utilizzo non risulta immediato




1 anno 4 numeri € 18,00 anziché € 20,00 Abbonati a Lattoneria
Periodico per il settore della lattoneria edile e della copertura metallica

Per abbonarsi è possibile sottoscrivere l’abbonamento online al link http://www.youtradeweb.com/abbonati-alle-riviste/ oppure, fare richiesta a abbonamenti@vgambinoeditore.it o telefonando al numero + 039 02 47761275 1 anno 4 numeri
€ 22,00 anziché € 28,00

https://www.virginiagambinoeditore.it/riviste/lattoneria/
Adibire uno spazio del sito internet condominiale con accesso esclusivo tramite password consente di gestire documenti e pagamenti in modo diretto ed efficace






Negli studi professionali può esercitare anche chi deve gestire una qualche disabilità. Ma non mancano le funzionalità che facilitano l’utilizzo di software e dispositivi informatici





SCARICARE A TETTO - IN CANNA FUMARIA - È QUALITÀ DI VITA!
• Resistenza alla corrosione della condensa acida certificata V2
• Tenuta della pressione P1 200 Pa
• Protezione al congelamento condense: isolamento 25 mm lana di roccia
• Canali da fumo PPs - protetto inox
• Installazione facile con gli elementi a misura - a taglio - telescopici
Scarica gratuitamente il Software Progetto Camino https://www.ancamini.it/download/an-progetto.html
• Progetta la canna fumaria collettiva anche con mix caldaie a condensazione e caldaie convenzionali
• Verifica il tiraggio e la temperatura di uscita fumi
• Favorisci la diluizione dei fumi in atmosfera garantendo un’adeguata velocità di uscita
Progetta, configura, preventiva velocemente la tua canna fumaria
• Accedi attraverso la piattaforma B2B - catalogo on-line
SCARICARE A PARETE IN FACCIATA...
• Formazione umidità sulle facciate
• Ritorno in ambiente fumi e vapori
• Rischio distacco intonaci e cappotti termici
• Fastidiosi pennacchi di vapore e gas di scarico
• Litigiosità tra condomini
• Pericolosa formazione di ghiaccio - condensa congelata








Internet è un mezzo potente per gestire il condominio, ma anche per attrarre nuovi clienti. Basta conoscere gli strumenti digitali da utilizzare (e sono gratuiti)






















































Per porre quesiti a Gaia Cigognini potete scrivere a info@vgambinoeditore.it
Buongiorno, le scrivo per avere un suo commento sul singolare comportamento del nostro amministratore condominiale specializzato in gaffe. O, più precisamente, in lapsus. Dire una cosa per l’altra può capitare a tutti, ma al nostro amministratore accade più volte durante ogni incontro, in particolare nelle assemblee di condominio. Un classico è lo scambio di nomi dei partecipanti, benché siano sempre gli stessi da anni. Ma questo è il meno. Capita anche che pronunci parole esattamente opposte a quello che, secondo lui, intendeva esprimere. Per esempio, può dire che il tal condomino si comporta in maniera sgradevole, ma quando glielo fanno notare dice che intendeva dire gradevole. Insomma, imbarazzante. Che ne pensa?
F.J. via e-mail
Quello che descrive potrebbe configurarsi come un classico caso che in psicanalisi è descritto come atto mancato o paraprassia: è un fenomeno psichico che consiste in un errore si vorrebbe compiere o dire una determinata cosa e invece si fa il contrario. Questo comportamento è stato descritto per la prima volta da Sigmund Freud quale dimostrazione che esiste una volontà dell’inconscio, che agisce a nostra insaputa e talvolta spinge a fare delle azioni che non razionalmente non vorremmo. Secondo Sigmund Freud gli atti mancati nascondono il conflitto nevrotico tra il compiere una certa azione e il non farla, un desiderio represso. In questo caso, sempre se fosse corretta questa interpretazione, il pensiero inconscio sarebbe quello espresso in modo palese attraverso i lapsus.
Egregia dottoressa, le sottopongo il caso di un nostro condomino che sta portando avanti la richiesta di un intervento edilizio per il nostro stabile. Il motivo è un breve (4 metri) tratto di corridoio in uno spazio comune che è chiuso da una vetrata. Questo condomino, che abita al sesto piano, sostiene di soffrire per questo passaggio perché sente l’irrazionale paura di cadere o perdere l’equilibrio (anche se c’è il vetro di protezione). Eppure, lo stesso afferma di non soffrire di vertigini, ma di essere preso dal panico solo in quel tratto di corridoio. Si tratta di una fantasia oppure di un reale problema?
Franco B. via e-mail
Non si tratta di una fantasia o di un vezzo: probabilmente la persona in questione è semplicemente acrofobica. Cioè, può sperimentare la paura di cadere o perdere l’equilibrio, percependosi quindi in pericolo quando si trova in luoghi elevati. Questa ansia può manifestarsi sia su sentieri di montagna che su passerelle che si affacciano su spazi vuoti. Inoltre, la paura può persistere anche quando è presente una protezione o una barriera, come ad esempio su un balcone domestico. Attenzione: non si tratta di vertigini, che è un disturbo che ha a che fare con la sensazione di equilibrio. In ogni caso, l’acrofobia si può curare.
Caro Psicondominio, spero che siate amici degli animali. In ogni caso, volevo segnalare la difficile situazione che vive il nostro condominio, dove risiedono diverse famiglie che possiedono cani. Nessuno di questi è una belva mordace e neppure si segnalano casi di animali che abbaiano disturbando i vicini. Eppure, c’è una donna, con un fisico anche piuttosto imponente, che appena ne avvista uno anche a molta distanza, anche se è tenuto al guinzaglio, si mette a urlare come se qualcuno volesse aizzare i cani a sbranarla. A nulla sono valse le rassicurazioni e il rispetto delle regole (cani al guinzaglio, a debita distanza): ogni giorno è la stessa scena. Che fare?
Gianna. S., via e-mail
La cinofobia è la paura irrazionale e persistente nei confronti dei cani. Questa paura può interferire con la vita quotidiana e causa attacchi di panico, con vertigini, sudorazione, mancanza di respiro e nausea. Come con altre fobie specifiche, chi soffre di cinofobia può mostrare un’ampia gamma di queste reazioni quando si confronta con un cane e, in alcuni casi, persino di fronte all’immagine (statica o filmata) di un cane. Ci sono, però, terapie specifiche, come quella di desensibilizzazione, che servono a ridurre o a eliminare l’ansia connessa con la visione o l’incontro tra il paziente e il migliore amico dell’uomo. La cattiva notizia è che secondo le statistiche solo il 12% al 30% di coloro che soffrono di una fobia specifica vuole sottoporsi a un trattamento per eliminarla.
































































Il servizio ChargeGuru fornisce soluzioni di ricarica per auto elettriche, installando un’infrastruttura senza alcun costo per il condominio, né impegni a carico degli amministratori. Dalla consulenza all’installazione, manutenzione e assistenza incluse pensa a tutto ChargeGuru, sinonimo di ricarica semplice, rapida e conveniente in tutta Europa.